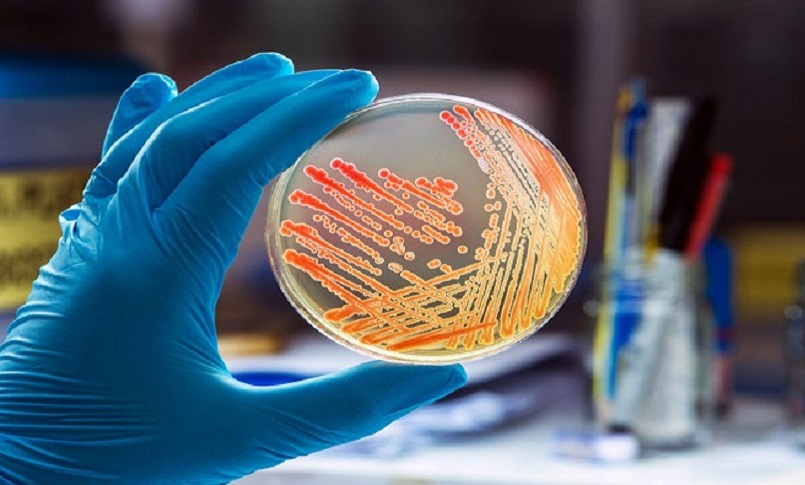

Quando si parla di batteri la distinzione tra Gram-positivi e Gram-negativi è una delle più importanti in microbiologia. Questa differenza non è solo accademica, ma ha implicazioni dirette sulla diagnosi delle infezioni e sull’efficacia degli antibiotici. Ecco tutto quello che c’è da sapere.
Che cosa distingue i Gram-positivi dai Gram-negativi?
La principale differenza tra batteri Gram-positivi e Gram-negativi risiede nella struttura della loro parete cellulare, che influenza:
- La colorazione con il metodo di Gram, utilizzato per identificarli al microscopio.
- La resistenza agli antibiotici.
- La loro virulenza e capacità di causare malattie.
Ecco un approfondimento sui principali aspetti distintivi:
1. Struttura della parete cellulare
Gram-positivi
- Possiedono una parete cellulare spessa, composta principalmente da peptidoglicano, uno strato robusto che fornisce resistenza e stabilità.
- Contengono acidi teicoici e acidi lipoteicoici, che svolgono ruoli strutturali e funzionali.
- Non hanno una membrana esterna.
Gram-negativi
- La loro parete cellulare è sottile e presenta un ridotto strato di peptidoglicano.
- Sono caratterizzati dalla presenza di una membrana esterna, ricca di lipopolisaccaridi (LPS), che agisce come una barriera protettiva contro antibiotici e agenti esterni.
- Hanno uno spazio periplasmico tra la membrana esterna e il peptidoglicano, che ospita enzimi importanti.
2. Metodo di Gram: come si colorano?
Il metodo di Gram è una tecnica di laboratorio che distingue i batteri in base alla capacità della loro parete cellulare di trattenere il colorante:
Gram-positivi
- Si colorano di blu o viola grazie al loro spesso strato di peptidoglicano, che intrappola il colorante cristallino violetto.
Gram-negativi
- Si colorano di rosa o rosso dopo la decolorazione con alcol o acetone e la successiva applicazione della safranina, un colorante di contrasto.
- La membrana esterna rende più facile la decolorazione.
3. Resistenza agli antibiotici
La struttura della parete cellulare influisce sulla sensibilità agli antibiotici:
Gram-positivi
- Sono generalmente più sensibili agli antibiotici che agiscono sul peptidoglicano, come la penicillina e altri beta-lattamici.
- Sono meno resistenti agli agenti fisici e chimici.
Gram-negativi
- Sono più resistenti grazie alla membrana esterna, che impedisce a molte molecole, inclusi antibiotici, di entrare.
- Possono produrre tossine chiamate endotossine (parte del lipopolisaccaride), che aumentano la loro virulenza.
4. Esempi di batteri Gram-positivi e Gram-negativi
Gram-positivi
- Staphylococcus aureus: causa di infezioni cutanee e polmoniti.
- Streptococcus pneumoniae: principale responsabile di polmoniti e otiti.
- Clostridium difficile: associato a infezioni intestinali gravi.
Gram-negativi
- Escherichia coli: spesso associato a infezioni urinarie.
- Salmonella enterica: causa di gastroenteriti.
- Pseudomonas aeruginosa: batterio resistente, responsabile di infezioni ospedaliere.
Perché è importante conoscere questa differenza?
Sapere se un’infezione è causata da un batterio Gram-positivo o Gram-negativo è fondamentale per scegliere il trattamento antibiotico più efficace. Ad esempio, molti antibiotici che funzionano bene contro i Gram-positivi sono inefficaci contro i Gram-negativi, a causa della barriera protettiva della loro membrana esterna. Inoltre alcuni Gram-negativi, come Pseudomonas aeruginosa, sono noti per essere particolarmente resistenti e difficili da trattare, rappresentando una sfida significativa per i medici.
Dell’Orco Mauro
Articoli correlati
- Occhio alle stanze d’albergo: sono piene di virus e batteri
- Cancro: ‘riprogrammare’ i batteri per attaccarlo
- Cefiderocol sicuro per alcune infezioni da batteri Gram-negativi
Scopri come guadagnare pubblicando la tua tesi di laurea su NurseTimes
Il progetto NEXT si rinnova e diventa NEXT 2.0: pubblichiamo i questionari e le vostre tesi
Carica la tua tesi di laurea: tesi.nursetimes.org
Carica il tuo questionario: https://tesi.nursetimes.org/questionari

Lascia un commento